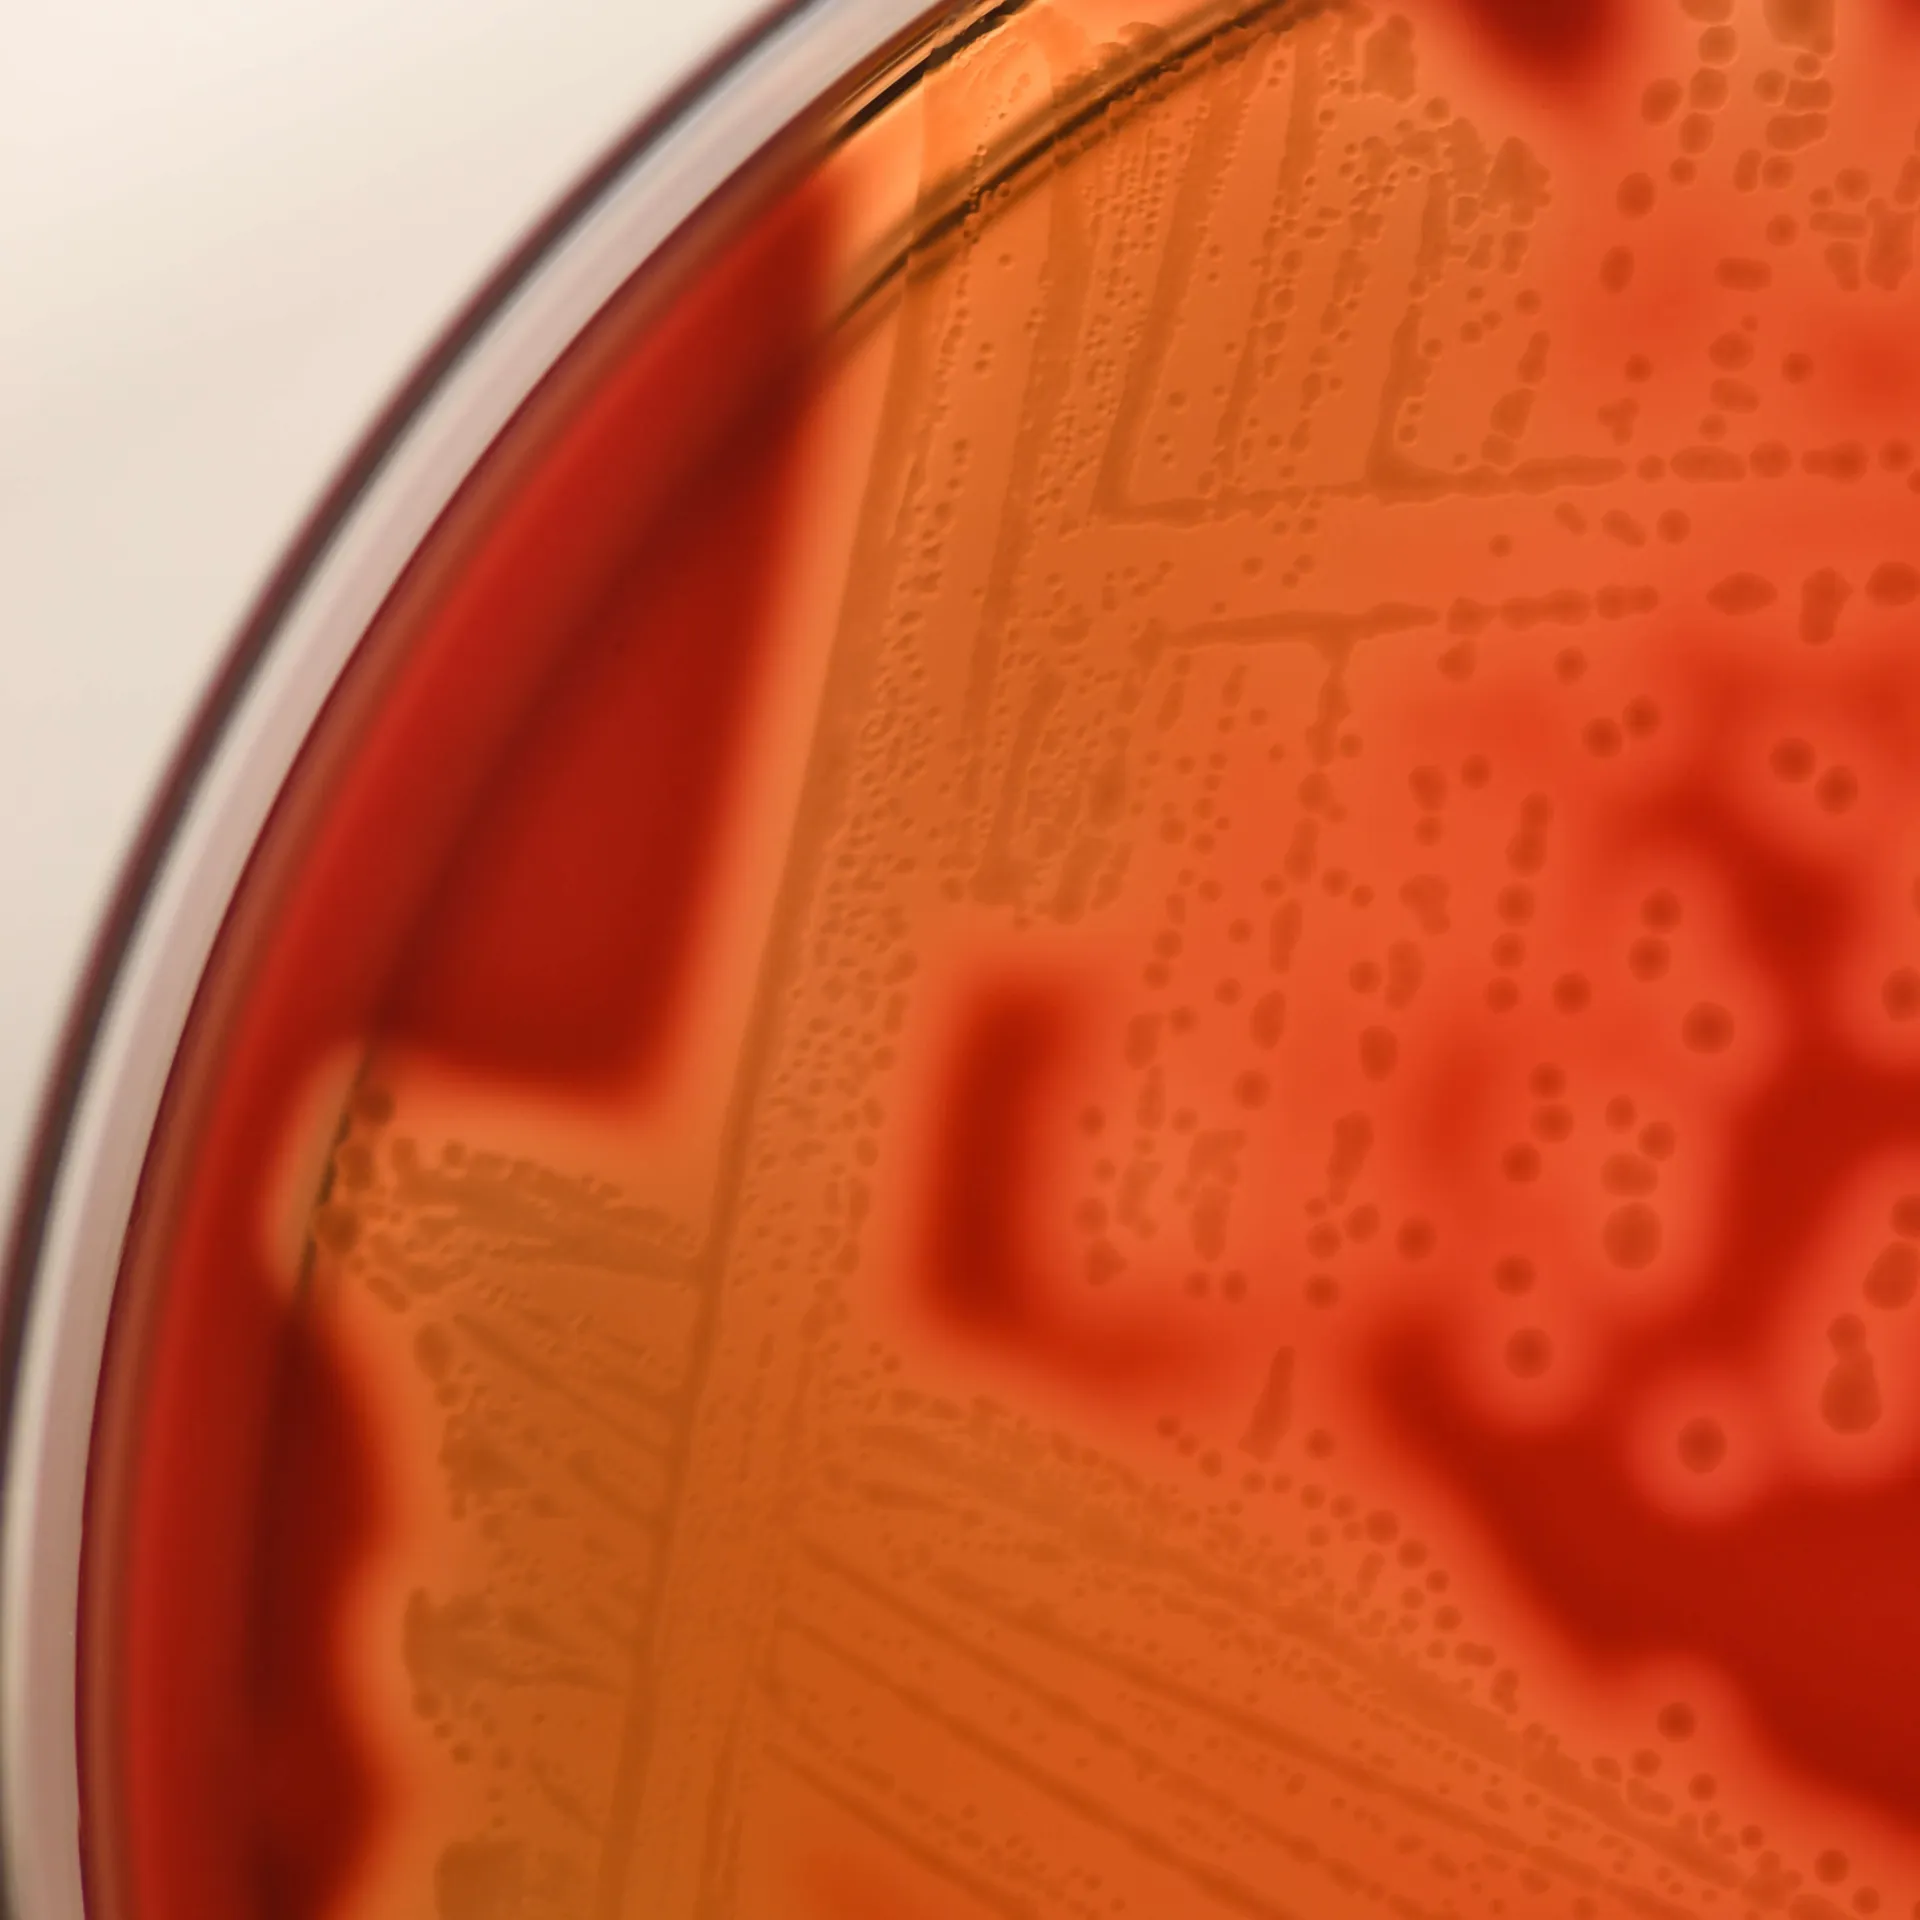
Bacteria growing on petri dish

Department of Biochemistry
Our faculty, students, and fellows are advancing science and medicine through transdisciplinary partnerships. We conduct innovative biomedical research using collaborative approaches that integrate biochemical, molecular, cellular, genetic, epigenetic, genomic, proteomic, and bioinformatic strategies.
Message from our Chair
The Department of Biochemistry drives global biomedical research in multiomics and multispectral imaging, focusing on genetics in cancer and cardiovascular diseases. Our graduates thrive in academia, clinical practice, and industry through robust research and mentorship.
Dr. Stein's Message
Biochemistry for Advanced Learners and Thinkers
The Biochemistry Graduate Program prepares students for careers in research and education, enhancing their chemistry and biochemistry knowledge while promoting critical thinking, creativity, and independent study.
Academic Programs
The Fundamentals of Research
Faculty in UVM’s Department of Biochemistry collaborate on diverse approaches to investigate fundamental biological questions at the molecular level in mechanistic and clinical contexts.
Biochemistry Research